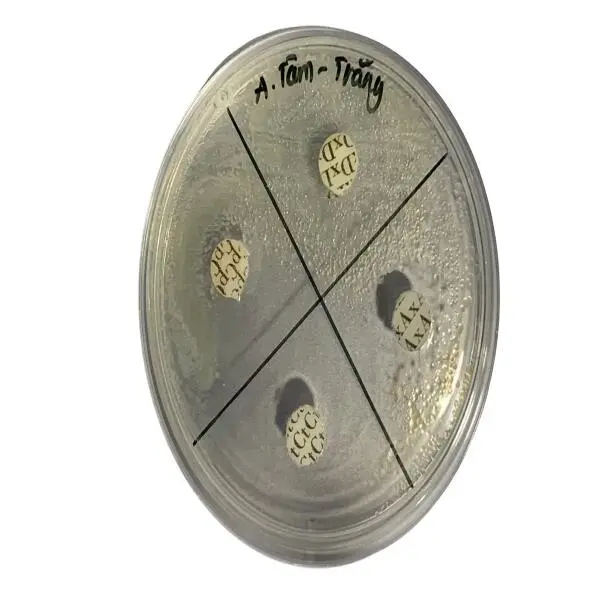
Tăng Cường Hiệu Quả Kháng Sinh Trong Nuôi Trồng Thủy Sản: Giải Pháp và Ứng Dụng

Nhận Dạng Tôm Khỏe Mạnh và Các Yếu Tố Ảnh Hưởng Đến Sức Khỏe
Trong nuôi tôm, việc xác định và duy trì sức khỏe của tôm là một yếu tố quan trọng để đảm bảo năng suất và hiệu quả của nghề nuôi trồng thủy sản. Tôm khỏe mạnh không chỉ phát triển tốt mà còn có khả năng chống chịu với các tác nhân gây hại như bệnh tật, thay đổi môi trường và những yếu tố stress. Để đạt được điều này, các yếu tố dinh dưỡng, môi trường sống và quy trình chăm sóc đóng vai trò quan trọng. Trong bài viết này, chúng ta sẽ cùng tìm hiểu các đặc điểm của tôm khỏe mạnh và cách nhận biết chúng, từ đó đưa ra các biện pháp chăm sóc thích hợp.
Các Đặc Điểm Cơ Bản Của Tôm Khỏe Mạnh
Màu Sắc Tôm
Màu sắc của tôm là một chỉ số quan trọng trong việc đánh giá sức khỏe của chúng. Tôm khỏe mạnh thường có màu sắc tươi sáng, đặc biệt là vỏ và phần cơ thể có độ bóng tự nhiên. Màu sắc có thể thay đổi tùy theo loài và môi trường sống, nhưng các tôm có màu sắc mờ hoặc thay đổi bất thường thường bị stress hoặc bị nhiễm bệnh.
- Tôm trắng khỏe mạnh: Tôm có màu sắc sáng, vỏ trong suốt, không có vết lở loét hay dấu hiệu nhiễm bệnh.
- Tôm đỏ khỏe mạnh: Những tôm màu đỏ tươi, đặc biệt là ở phần vỏ và cơ thể, thể hiện sự phát triển tốt và đủ dinh dưỡng.
Hình Dáng và Kích Cỡ
Tôm khỏe mạnh thường có hình dáng thẳng, cơ thể không bị biến dạng. Các bộ phận của tôm như vỏ, mắt, đuôi và chân phải phát triển đồng đều. Tôm có kích cỡ phù hợp với độ tuổi và không có dấu hiệu suy dinh dưỡng hay còi cọc.
- Vỏ chắc chắn: Vỏ tôm không bị mềm hay dễ vỡ. Nếu tôm có vỏ mềm, đây có thể là dấu hiệu của việc thiếu khoáng chất hoặc yếu tố vi lượng.
- Phát triển đồng đều: Tôm khỏe mạnh có tỷ lệ phát triển các bộ phận cơ thể đồng đều. Các chi như chân, anten, càng phát triển tốt và không có dấu hiệu bị suy yếu.
Mắt và Các Bộ Phận Cảm Quang
Mắt tôm khỏe mạnh có màu sắc trong suốt và rõ nét, không bị mờ hay có dấu hiệu nhiễm khuẩn. Các bộ phận cảm quang của tôm như anten và cảm giác chân có thể giúp tôm nhận biết môi trường xung quanh, do đó, khi tôm khỏe mạnh, các bộ phận này sẽ hoạt động linh hoạt, nhanh nhẹn.
Hệ Diễn Biến Vỏ
Tôm có khả năng thay vỏ để lớn lên, điều này gọi là lột xác. Quá trình lột xác diễn ra thường xuyên và đều đặn ở tôm khỏe mạnh. Sau khi lột vỏ, tôm có một lớp vỏ mới sáng bóng, cứng cáp hơn. Quá trình lột xác này cho thấy tôm đang phát triển bình thường và không gặp phải vấn đề về dinh dưỡng hay bệnh tật.
- Lột xác thường xuyên: Tôm khỏe mạnh sẽ có khả năng lột xác định kỳ, giúp chúng lớn nhanh và phát triển tốt hơn.
Các Dấu Hiệu Nhận Biết Tôm Khỏe Mạnh
Tôm Di Chuyển Nhanh Nhẹn
Tôm khỏe mạnh thường di chuyển rất linh hoạt trong nước, đặc biệt là khi có điều kiện môi trường tốt. Những tôm này phản ứng nhanh với các tác nhân xung quanh, như thay đổi ánh sáng hoặc sự xuất hiện của mồi. Khi tôm di chuyển chậm, không đều hoặc thường xuyên nằm im, đó có thể là dấu hiệu của vấn đề sức khỏe.
Hệ Thống Tiêu Hóa Hoạt Động Tốt
Tôm khỏe mạnh có hệ thống tiêu hóa hoạt động bình thường. Khi ăn, tôm sẽ có xu hướng tìm kiếm thức ăn một cách nhanh chóng và tiêu hóa tốt. Những dấu hiệu của một hệ tiêu hóa yếu có thể là việc tôm ăn ít hoặc có hiện tượng bỏ ăn, hệ tiêu hóa không hoạt động đúng cách.
- Kết quả tiêu hóa: Sau khi tôm ăn, phân tôm sẽ có màu sắc bình thường (thường là màu nâu hoặc đen) và không có mùi lạ.
Tôm Có Hành Vi Xã Hội Bình Thường
Tôm là loài động vật có tính xã hội cao và có thể sống theo nhóm. Tôm khỏe mạnh sẽ tương tác tốt với những tôm khác trong đàn. Nếu tôm thường xuyên tách biệt khỏi nhóm hoặc có hành vi hung hãn (cắn nhau), điều này có thể cho thấy chúng không khỏe mạnh, có thể do bệnh tật hoặc điều kiện môi trường không phù hợp.
Phản Xạ Đối Phó Với Các Yếu Tố Môi Trường
Tôm khỏe mạnh có khả năng phản xạ linh hoạt đối với các yếu tố môi trường, chẳng hạn như thay đổi nhiệt độ, ánh sáng hoặc mực nước. Tôm sẽ nhanh chóng lẩn tránh hoặc thay đổi vị trí khi có sự xuất hiện của các yếu tố gây stress. Nếu tôm không phản ứng hoặc có phản ứng chậm chạp, có thể là dấu hiệu sức khỏe kém.
Các Yếu Tố Ảnh Hưởng Đến Sức Khỏe Của Tôm
Chế Độ Dinh Dưỡng
Dinh dưỡng là yếu tố quan trọng nhất giúp tôm phát triển khỏe mạnh. Tôm cần một chế độ ăn đầy đủ chất đạm, vitamin, khoáng chất và các dưỡng chất cần thiết để duy trì sức khỏe. Việc cung cấp thức ăn không đầy đủ hoặc không chất lượng sẽ dẫn đến tình trạng suy dinh dưỡng và phát triển kém.
- Thức ăn chất lượng: Cung cấp thức ăn tươi, sạch và có đủ chất dinh dưỡng sẽ giúp tôm phát triển khỏe mạnh.
- Chế độ ăn hợp lý: Các chuyên gia khuyến nghị nên cung cấp thức ăn cho tôm nhiều lần trong ngày và điều chỉnh theo sự phát triển của tôm.
Điều Kiện Môi Trường
Môi trường sống của tôm ảnh hưởng trực tiếp đến sức khỏe của chúng. Nước trong ao nuôi phải được duy trì ở các mức lý tưởng về pH, nhiệt độ, độ mặn, oxy hòa tan và các yếu tố khác. Các yếu tố này phải được kiểm soát để tránh gây stress cho tôm, dẫn đến giảm sức đề kháng và phát sinh bệnh tật.
- Chất lượng nước: Đảm bảo nước trong ao luôn sạch, có đủ oxy hòa tan và pH ổn định.
- Điều kiện nhiệt độ: Nhiệt độ nước cần phải duy trì trong phạm vi thích hợp cho loài tôm đang nuôi.
Quản Lý Môi Trường Sống
Bên cạnh chất lượng nước, việc kiểm soát mực nước trong ao và không gian sống của tôm cũng rất quan trọng. Tôm cần không gian đủ rộng để di chuyển và tìm kiếm thức ăn. Quá đông đúc trong ao nuôi có thể gây stress và gia tăng nguy cơ bệnh tật.
Phòng Ngừa và Điều Trị Bệnh
Bệnh tật là yếu tố chủ yếu làm suy yếu sức khỏe của tôm. Các bệnh do vi khuẩn, virus hoặc ký sinh trùng có thể tấn công tôm, làm suy yếu sức khỏe của chúng. Việc phát hiện sớm và điều trị kịp thời các bệnh là rất quan trọng.
- Kiểm tra sức khỏe thường xuyên: Các biện pháp phòng ngừa bệnh tật, bao gồm tiêm vaccine và sử dụng chế phẩm sinh học, giúp giảm thiểu nguy cơ mắc bệnh cho tôm.
Tôm khỏe mạnh là yếu tố then chốt để đạt được năng suất cao trong nuôi trồng thủy sản. Nhận biết các đặc điểm của tôm khỏe mạnh và duy trì môi trường nuôi lý tưởng, chế độ dinh dưỡng hợp lý là những yếu tố quan trọng giúp tôm phát triển tốt. Cùng với việc phòng ngừa bệnh tật và chăm sóc đúng cách, chúng ta có thể duy trì một hệ sinh thái nuôi tôm khỏe mạnh và bền vững.